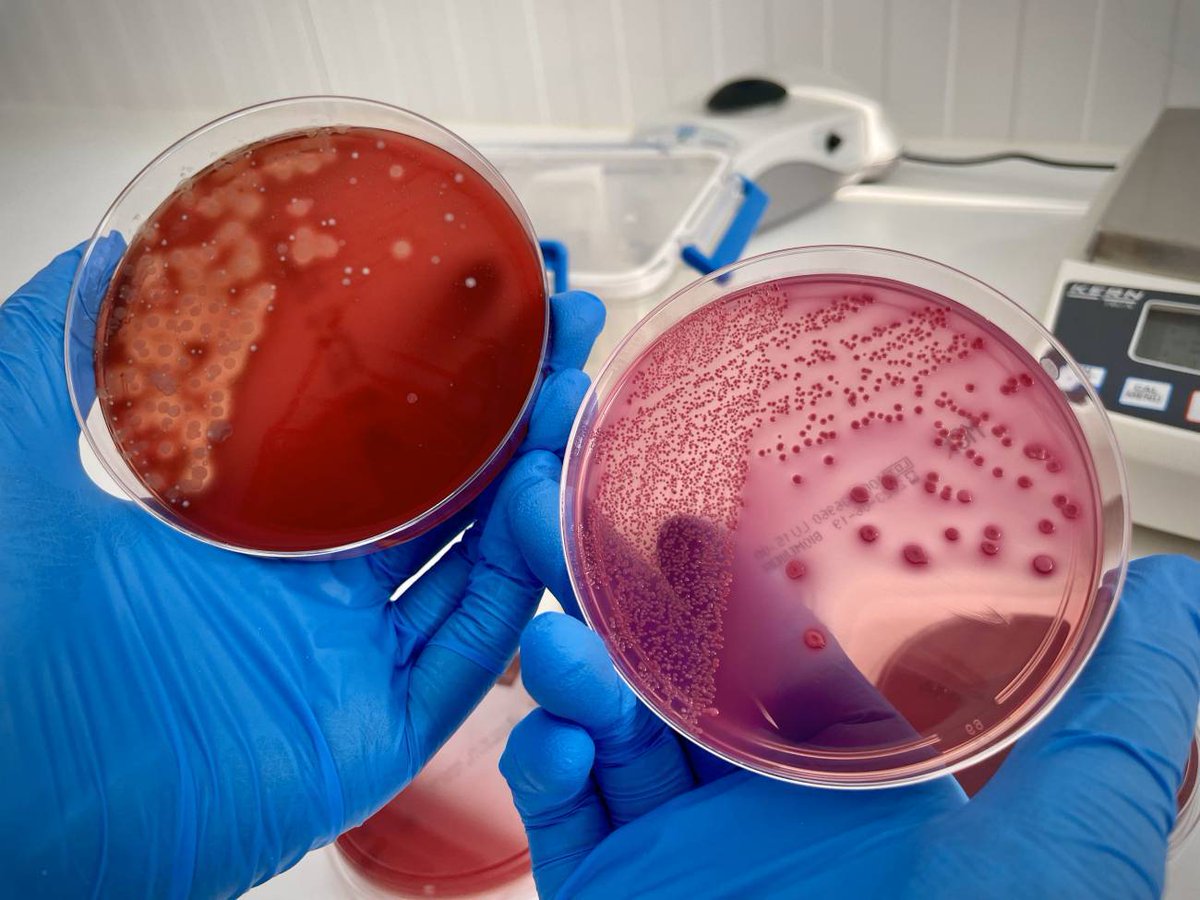
En la actualidad “hay más de 450 ensayos clínicos activos con trasplante de microbiota humana para diversas patologías”, destaca la microbióloga Andrea Aira del <a href="/hospitalclinic/">Hospital Clínic</a> 

✍️ <a href="/saez_cristina/">Cristina Sáez</a> 

🧫 agenciasinc.es/Reportajes/Cua…

Clara Ballesté
@clarinsbd
Microbiologist, PhD. Interested in antimicrobial resistance. Convinced (hopefully, as many others!) that local actions have global consequences. Love travelling
ID: 733399435317678080
19-05-2016 20:50:26
684 Tweet
196 Takipçi
198 Takip Edilen


Cristina Pitart ha presentado un estudio en colaboración con IdISBa HU Son Espases sobre la persistencia de un clon de P.aeruginosa NDM-1 ST773 en nuestro centro introducida por una paciente transferida de Ucrania! Cristina Pitart SEIMC Hospital Clínic



En la actualidad “hay más de 450 ensayos clínicos activos con trasplante de microbiota humana para diversas patologías”, destaca la microbióloga Andrea Aira del Hospital Clínic ✍️ Cristina Sáez 🧫 agenciasinc.es/Reportajes/Cua…

Nuestra compañera Andrea Aira ha participado en este repotaje sobre microbiota 👇 Banc Microbiota Catalunya. Seu Clínic


El Monitor de Reputación Sanitaria (MRS) entregando los premios de reputación sanitaria al CORE y a Anatomia Patológica del #CDB, Hospital Clínic según datos del último ranking #MRS, #MERCO. Enhorabuena a todo el equipo!! Aurea Mira Vallet, Clara Ballesté


Formar part d'un equip Unitat d’Alzheimer i altres Trastorns Cognitius i un centre Hospital Clínic que cada dia treballa per millorar la qualitat assistencial que oferim a les persones amb alteració cognitiva, és una gran satisfacció. Moltes gràcies equip!! Seguim!😀 ⬇️⬇️






🌊🔬 'Aguas regeneradas de calidad: STOP bacterias resistentes a los antibióticos' ha sido uno de los 5 proyectos #DKVImpacta seleccionados. 🫶🏽 ¡Gracias, DKV Salud (ES) e Impact Hub Barcelona, por impulsar la investigación! #AMR #Microbiología cc sara maria consalud.es/salud35/nacion…


Resistencias microbianas a los antibióticos, ¿dónde estamos? 💬"Además de mayor regulación y monitoreo, hay que aumentar la concienciación a nivel médico, político y de la población general" – sara maria (#ISGlobal) cc Biomedicina BCN ellipse.prbb.org/es/resistencia…

.Anna Sellarès recién terminada su formación BIR, presenta su trabajo de PCR digital en la Escuela de Verano de la SEIMC. SEIMC Miriam ALVAREZ






